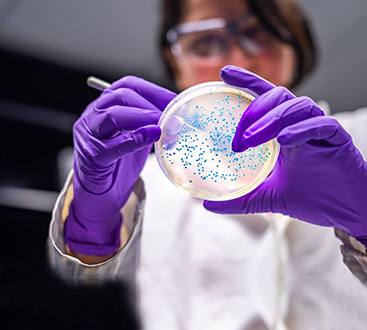

Who We Are
We’re dedicated to give you the very best of Sodium Silicate, with focus on Quality & the best
customer service through
our premium product. We are now ready serve customers in domestic and all over the
world, and are thrilled to be a part of the fair trade in this silicate industry.
Silicates for every Application
Our products have a versatile application range with different chemical compositions suitable as medium binder, de-inker, core mold, pH component, hardener and many more. Our products find application to be used in the following.
Quality
At VSVR, we're deeply committed to quality
products, competitive pricing and unparalleled
customer service for your immediate requirements. Our
experienced sales and production teams can quickly and
efficiently deliver the most demanding specifications in
the shortest possible times at the most competitive prices.

Our most important goal to archive...
“Total customer satisfaction through our Premium
Product with Continuous, Constant Supply & Support..."